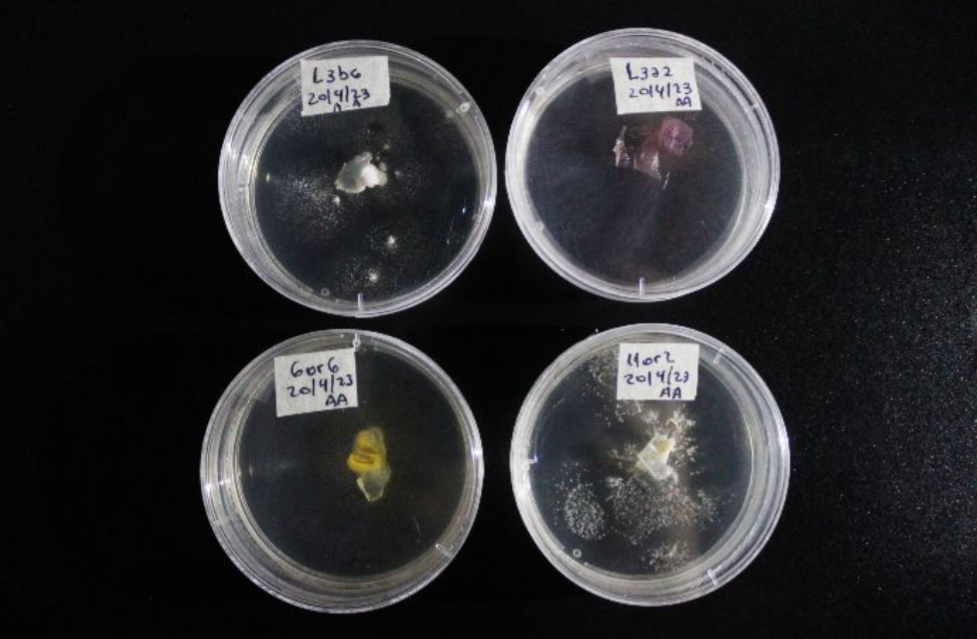

Fuente: Noticias Científicas de la UNQ
Las investigadoras del Laboratorio de Entomología Forense de la Universidad Nacional de Quilmes (UNQ) emplean las pistas que dejan los insectos para determinar cuándo y en qué hábitat fallece un cuerpo. Esto ayuda a resolver muertes dudosas.
Las moscas suelen ser molestas: vuelan sobre las comidas, se apoyan en el cuerpo y zumban. Sin embargo, constituyen una parte fundamental a la hora de desentrañar los misterios alrededor de un crimen porque son los primeros insectos en llegar y colonizar un cuerpo en descomposición. No sólo se trata de seres humanos, sino que abarca todo tipo de vertebrados, como reptiles, aves, peces, anfibios y mamíferos. Estudiar la fauna que llega a los cadáveres permite obtener información sobre cómo y cuándo murió ese ser vivo, y de esto se encargan en el Laboratorio de Entomología Aplicada y Forense de la UNQ.
“Investigamos cuáles son las especies de moscas que colonizan cuerpos en descomposición porque nos permiten indagar cuándo fue la fecha aproximada en que ese organismo falleció”, cuenta Mónica Chirino, directora del Laboratorio y docente de la UNQ,
«Cuando un cadáver queda expuesto al accionar de los insectos, estos empiezan a colonizarlo: las moscas ponen huevos, que luego se desarrollan como larvas y se alimentan del cuerpo. Más tarde, llega otro tipo de fauna como escarabajos y moscas de distintas especies, estudiar a las moscas nos permite hacer un viaje en el tiempo: Si estudiamos ese cuerpo, va a tener ciertas características. Puede estar hace poco o hace mucho, desnudo o vestido, apuñalado o enterrado. Lo que tenemos que descubrir es cuánto hace que está allí. Entonces, como las moscas son las primeras que lo detectan y ponen sus huevos que luego serán larvas, nosotros debemos identificar la especie de la que se trata y contrastar con los datos que tenemos en el laboratorio”.

Según el lugar y el momento del año en el que muere el vertebrado, serán los tipos de moscas que primero pongan huevos. Así, por ejemplo, en el área urbana de la zona sur de Buenos Aires las moscas que más abundan se llaman “Lucilia sericata” (mosca verde metálica) y “Lucilia cuprina” (mosca color bronce) y en menor medida “Lucilia ochricornis”.
Bajo este marco, la investigadora de Conicet continúa el ejemplo. “Hay moscas que son rurales y otras que son urbanas. Entonces, si el cuerpo aparece en el campo pero tiene huevos de moscas de ciudad eso quiere decir que fue trasladado y no es allí donde ocurrió la muerte, así como también si tiene huevos o larvas de épocas de calor y ya hace frío quiere decir que falleció hace un tiempo”.

¿Sobreviven al agua?
Dentro del Laboratorio de Entomología Aplicada y Forense, Lucila Salanitro, licenciada en Biotecnología de la UNQ y becaria doctoral de Conicet, indaga sobre el desarrollo de las larvas de la mosca Lucilia sericata en un contexto de sumersión. “Encontramos que los huevos de esta mosca (que son de aire) sobreviven en el agua hasta seis horas y su desarrollo hasta convertirse en larva no se ve afectado. Es una sumersión parcial, es decir, un tiempo dentro del agua y otro afuera. Es como si hubieran arrojado un cuerpo al río y la marea lo hubiera sacado a la superficie. Lo que permiten estos resultados es considerar las posibilidades. Por caso, si los huevos no sobrevivieron es porque el cuerpo estuvo más de seis horas sumergido, o si están presentes los huevos de esta especie de mosca que no es acuática es porque el cuerpo falleció en la tierra y luego se trasladó al agua”, detalla Salanitro.
Para llegar a este resultado, la investigadora puso huevos de moscas madres en pedazos de carne, los sumergió a distintas alturas (25 cm, 15 cm y 5 cm) y durante diferentes intervalos de tiempo, los sacó y dejó que el desarrollo vital de las larvas continúe a temperatura ambiente.

Los hongos también ayudan
Si la investigación que realiza Salanitro comienza al tiempo de que el cuerpo fallezca, la de Anabella Massaccesi se encuentra en la otra punta del camino, cuando ya pasaron varios años de la muerte. Ella realiza su tesis de la licenciatura en Biotecnología en este laboratorio y caracteriza diferentes hongos que aparecen en los restos óseos tras un largo tiempo de estar enterrados. Para ello, trabaja en las exhumaciones que se realizan en el Cementerio de Ezpeleta:
“La idea es poder determinar cuánto tiempo de inhumación tiene la persona. Estamos hablando de años por lo que a veces quedan restos óseos, como una mandíbula, y a veces no queda nada. Cada cierto tiempo, el cementerio pasa los restos de tumbas a una fosa común. Entonces, con los permisos requeridos, agarro los huesos, los rasqueteo con hisopos estériles y esas muestras las llevo al laboratorio”.
Anabella Massaccesi caracteriza diferentes hongos que aparecen en los restos óseos tras un largo tiempo de estar enterrados.
A través de distintos materiales, la tesista evalúa el desarrollo de cada hongo y realiza una caracterización.
De lo micro a lo macro, la entomología forense trabaja con elementos muy pequeños pero que cobran vital importancia en la amplia labor conjunta que realizan detectives, policías y jueces.

Lucila Salanitro con Mónica Chirino (izq.) y Néstor Centeno (der.), directores del Laboratorio de Entomología Aplicada y Forense. Créditos: Agencia de Noticias Científicas de la UNQ.